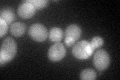
YHR135C
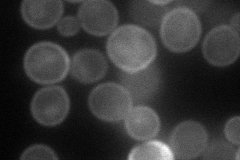
YHR135C
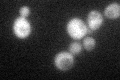
YHR135C
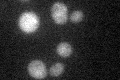
YHR135C

View description
Palmitoylated plasma membrane-bound casein kinase I isoform; shares redundant functions with Yck2p in morphogenesis, proper septin assembly, endocytic trafficking; provides an essential function overlapping with that of Yck2p
Localization:
Intensity:
Fold change:
Significance:
-
C’ GFP library in SD
cytosol44.75 -
N' NOP1pr-GFP in SD

cell periphery83.795 -
N' TEF2pr-mCherry in SD
cell periphery59.2027 -
N' NATIVEpr-GFP in SD

below threshold16.5461 -
N' TEF2pr-VC and Cyto-VN in SD

cytosol29.3418 -
C’ GFP library in SD+DTT

cytosol40.160.89No -
C’ GFP library in SD+H2O2
cytosol45.171No -
C’ GFP library in Starvation Media
cytosol35.380.79No -
C’ GFP library on the background of Pup2-DaMP

N/A -
C’ GFP library on the background of CCT mutant

N/A0N/AYes
